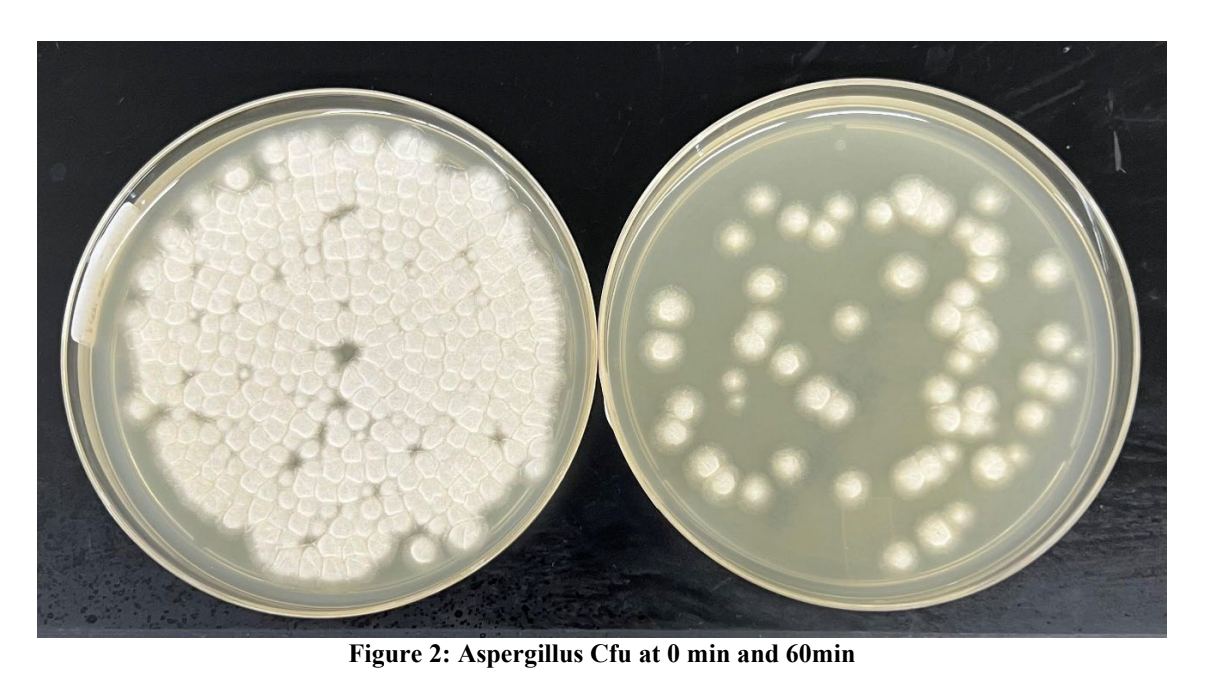

Jaspr vs Mold
September 02, 2024
JASPR VS. MOLD
Okay, this is really exciting stuff, prepare to be mind blown! 🤯
The EPA required us to do a 3rd party lab study on mold in order for us to make scientific claims.
So, we hired a laboratory called LMS technologies to run a study for us.
1st step: They filled the air with millions of mold spores
2nd step: They turned on Jaspr
3rd step: They monitored the airborne levels of mold for 60 minutes
Here is a photo of a petri dish mold sample ONLY 60 minutes after running the Jaspr in a 500 square foot room. 👇

CONCLUSION
Jaspr 1, Mold 0.
In a short 60 minutes Jaspr removed 87% of mold spores in the room.
At this rate, the air would have 98% less mold in 3 hours and 99.9% less mold in 24 hours.
Reminder: MOLD is everywhere, it's inside, its outside and in our modern indoor environments mold gets trapped inside and can't escape.
This is why I started Jaspr, and why I consider filtering your air to be the single most important step to living a healthier life.
HERE IS THE PROOF
As always, we believe in 100% transparency so here is the link to actual lab results.
____________________________________________________________________
Thanks for reading.
It is my honor to be able to use my previous experience in mold remediation to create the world's only air purifier that is commercial in strength but has the aesthetic and beauty that your home deserves.
Thank you for reading.
mike 🙏